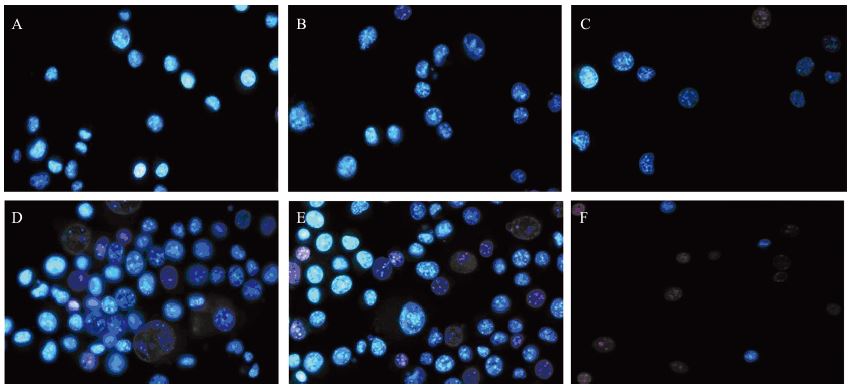

文章信息
- 扎拉嘎胡,刘英富,兰晓霞,陈小义. 2014.
- ZHALA Gahu, LIU Yingfu, LAN Xiaoxia, CHEN Xiaoyi. 2014.
- 蟾蜍灵对B16细胞增殖及凋亡的影响
- Effects of Bufalin on Proliferation and Apoptosis of Melanoma Cells B16
- 肿瘤防治研究, 2014, 41(10): 1078-1081
- Cancer Research on Prevention and Treatment, 2014, 41(10): 1078-1081
- http://www.zlfzyj.com/CN/10.3971/j.issn.1000-8578.2014.10.005
-
文章历史
- 收稿日期:2013-07-29
- 修回日期:2013-10-30
2. 救援医学系流行病与统计学教研室
2. Department of Army Epidemiology and Statistic
恶性黑色素瘤发病增长率呈逐年上升的趋 势,它转移早、进展快、预后差、死亡率高,至 今还没有治疗黑色素瘤的特效药。近年来大量的 实验研究表明,多种中药具有抗肿瘤和诱导肿瘤 细胞调亡的作用。蟾蜍是我国传统的中药材,很 早就有蟾蜍全虫或蟾酥内服及外用治疗瘸瘕积 聚、痰注、恶疮等类似肿瘤疾病的记载。蟾蜍灵 (Bufalin,二羟蟾毒二烯酸内脂)是从中药蟾酥中提 取的一种毒性配基,研究证明,蟾蜍灵在体外对 人白血病、胃癌[1, 2]及肝癌细胞生长均具有抑制作 用。蟾蜍灵可以明显抑制前列腺癌细胞株DU145、 LNCaP和PC3的增殖,并促进其发生凋亡[3, 4, 5]。我们 课题组前期研究也发现Bufalin具有抑制体外培养 癌细胞系的增殖和促进其凋亡作用[6, 7]。本实验旨 在研究Bufalin对B16细胞生长、细胞周期及凋亡的 影响。 1 材料与方法 1.1 主要试剂
B16细胞购自中国科学院上海细胞生物研究 所。RPMI1640培养液购自美国Gibco公司,胎牛 血清购自民海生物公司,胰蛋白酶(1 :250)购 自美国Gibco公司,蟾蜍灵(Bufalin)、碘化丙啶 (PI)、噻唑蓝(MTT)和二甲基亚砜(DMSO) 均购自Sigma公司,5410 CO2培养箱购自美国Napco 公司,SW-CZ-ZFO超净工作台购自苏州安泰空气技术有限公司,SUNRISE全自动酶标仪购自奥地 利Tecam公司。 1.2 MTT法检测Bufalin作用后B16生长抑制率
取对数生长期B16细胞用0.25%胰酶消化制成5× 104 cells/ml细胞悬液,接种于96孔板,每孔100 μl,常 规培养24 h,待细胞70%~80%汇合后,药物处理。 实验组分别加入Bufalin 0.1、1、10、100 μmol/L, 同时设正常对照组(有细胞不加药)和空白对照组 (只有培养液,不加细胞),作用24、48和72 h后, 加入MTT 20 μl(终浓度5 g/L),继续培养4 h,1 500 g 离心10 min,弃上清液,每孔加150 μl DMSO,避光振荡 混匀,酶标仪测定(Bio-Rad 550型)其A490值。按公式 计算细胞生长抑制率:抑制率(%)=(A正常对照-A实验)/ (A正常对照-A空白对照)×100%。数据采用加权直线线性回 归法求得细胞生长抑制率为50%时的药物浓度。 1.3 荧光显微镜观察细胞凋亡
设实验组和对照组,实验组为取对数生长的细 胞加入2 μmol/L Bufalin作用24、48 h。对照组不加 药。细胞消化离心收集细胞,PBS洗涤2次后重悬 于200 μl PBS中,加入20 μl Hoechst33342(终浓度10 μg/ml),在37℃培养箱中染色10 min,1 000 r/min离 心10 min,弃上清液,加入适量PBS,吹打混匀,滴 片,在荧光显微镜下观察细胞染色质凝集形态。 1.4 流式细胞术检测细胞周期
取对数生长期的B16细胞传代培养24 h后加药 处理,实验组分别加入1、2 μmol/L的Bufalin作用 24、48 h。对照组不加药。用0.25%胰蛋白酶消化 后,用预冷PBS洗涤,收集1×106个细胞,制成单 细胞悬液,4℃预冷的75%乙醇4℃固定过夜。加入 PBS离心洗2次后,加入碘化丙啶(PI)100 μg/ml (含Rnase终浓度为50 μg/ml),4℃避光染色30 min,进行流式细胞仪检测细胞周期各时相细胞 比率,并计算细胞增殖指数(proliferation index, PI),PI=(S+G2/M)/(G0/G1+S+G2/M)×100%。 1.5 统计学方法
数据用x±s表示,采用SPSS13.0软件进行单 因素方差分析(ANOVA)和析因方差分析,以P <0.05为差异有统计学意义。 2 结果 2.1 Bufalin作用后倒置荧光显微镜观察细胞形态
对照组细胞生长饱满,透光性好,2 μmol/L Bufalin作用24 h后细胞折光性变差、48 h后细胞明 显肿胀,细胞表面变得粗糙,培养液中出现死亡 的漂浮细胞,见图 1。

|
| A: control group; B: 2μmol/L 24h Bufalin group; C: 2μmol/L 48h Bufalin grouP</span> 图 1 Bufalin作用B16细胞后形态变化( ×100) Figure 1 The morphological changes of melanoma cells B16 treated with Bufalin ( ×100) |
采用MTT评价不同浓度的Bufalin(F=399.826, P<0.01)和作用时间(F=38.293,P<0.01)比较均 有统计学意义,LSD法进一步两两比较结果显示, Bufalin同浓度不同时间差异显著(P<0.01),在24 h 内有抑制效果,48 h最强,到72 h时抑制效果降低。 100 μmol/L与10 μmol/L、10 μmol/L与1 μmol/L间 差别无统计学意义(P>0.05),其余各浓度组间差 异均有统计学意义(P<0.01)。72 h时0.1 μmol/L 浓度抑制率可达16.4%,而10 μmol/L浓度抑制率达 50.73%。24、48、72 h的IC50值分别为37.80、6.00、 9.12 μmol/L。综合析因方差分析结果显示:Bufalin 浓度为10 μmol/L、作用48 h,对B16细胞抑制效果 最强,见表 1。
 |
| Notes: *: P<0.01, comparison at the different time points; a, b, c and d: P>0.05, comparison at the different concentrations, between the same alphabets, P<0.01, between the different alphabets |
Hoechst33342染色后荧光显微镜观察,对照 组细胞形态规整,细胞核均匀。实验组1 μmol/L Bufalin作用24 h,部分细胞呈现形态不规则、细胞 核固缩,核染色质凝集、细胞膜肿胀、边缘化、 产生凋亡小体,呈凋亡细胞形态;Bufalin对B16细 胞凋亡具有浓度和时间依赖性,见图 2。
|
| A: control group; B: 1μmol/L 24h Bufalin group; C: 2μmol/L 24h Bufalin group; D: 1μmol/L 48h Bufalin group; E: 2μmol/L 48h Bufalin group; F: 2μmol/L 72h Bufalin grouP</span> 图 2 荧光显微镜观察细胞形态改变( ×200) Figure 2 Morphological changes of B16 melanoma cells under fluorescence microscopy( ×200) |
与对照组相比Bufalin组可引起B16细胞G0/G1期 阻滞。1 μmol/L Bufalin作用48h后培养细胞中G0/G1 期细胞比例由(74.5±0.25)%增加到(83.6±0.16)%(P< 0.01)。Bufalin对G0/G1期阻滞随作用时间延长 而增强。比较细胞增殖指数(PI)发现Bufalin干预 后与对照组比较48 h降低,见表 2,图 3。
 |
| Notes: *: P<0.05, compared with the control group, with LSD method |

|
| A, D: control group; B: 24h 1μmol/L Bufalin group; C: 24h 2μmol/L Bufalin group; E: 48h 1μmol/L Bufalin group; F: 48h 2μmol/L Bufalin grouP</span> 图 3 Bufalin对B16细胞作用后流式检测细胞周期 Figure 3 Cell cycle of melanoma cell B16 treated with Bufalin analyzed by flow cytometry |
中药及其有效成分因其价格低廉、来源广 泛、应用历史悠久等优点在肿瘤防治方面的作用 越来越受到人们的重视。蟾蜍作为我国传统中药 之一,在治疗白血病及胃癌、肝癌、结肠癌等多 种消化系统肿瘤中得到了临床运用。Bufalin是从 蟾蜍中分离提取的抗癌有效单体,近年来更是得 到广泛研究,国内外研究已证实,中药蟾蜍灵具 有明显抑制肿瘤增殖的作用[8, 9],它能通过多种途 径诱导肿瘤细胞分化和凋亡[10, 11, 12],对白血病细胞 有极强的抑制作用[13],对人绒膜癌、乳腺癌、肺 癌、结肠癌、血管内皮细胞也有增殖抑制和凋亡 的作用[14, 15, 16, 17, 18, 19]。
本研究通过检测Bufalin对B16细胞增殖和凋亡 作用发现,Bufalin可抑制B16细胞的增殖,其抑 制作用与作用时间及作用浓度相关,同时研究结 果还表明Bufalin可诱导B16细胞凋亡,此作用存 在剂量效应依赖性。荧光染色观察显示2 μmol/L Bufalin作用24 h后,可诱导B16细胞产生凋亡。流 式检测细胞周期发现Bufalin对B16细胞G0/G1期阻 滞。Bufalin 对B16细胞具有抑制增殖及促进凋 亡作用,此作用是Bufalin抑制B16细胞增殖并诱 导其凋亡的机制之一,从而发挥Bufalin的抗肿 瘤作用。
综上所述,本试验证明了Bufalin对B16细胞的 增殖抑制及诱导凋亡能力,为Bufalin的临床应用 提供了实验依据,Bufalin在黑色素瘤的治疗方面 是一种有应用前景的抗肿瘤药物。
| [1] | Li D, Qu X, Hou K. PI3K/Akt is involved in bufalin-induced apoptosis in gastric cancer cells[J]. Anticancer Drugs, 2009, 20(1): 59-64. |
| [2] | Zhang Y, Tian X, Liu YP, et al. Effects of bufalin on proliferation and apoptosis of SGC7901/CDDP and its underlying mechanisms[J]. Xi’an Jiao Tong Da Xue Xue Bao(Yi Xue Ban), 2012, 33(4): 498-500, 514. [张晔, 田昕, 刘云鹏, 等. 蟾蜍灵对顺 铂耐药胃癌SGC7901细胞增殖与凋亡的影响及其作用机制[J]. 西安交通大学学报(医学版), 2012, 33(4): 498-500, 514.] |
| [3] | Yen JY, Huang WJ, Kan SF, et al. Effects of bufalin and cinobufagin on the proliferation of androgen dependent and independent prostate cancer cells[J]. Prostate, 2003, 54(2):112-24. |
| [4] | Effenrth T, Davey M, Olbrich A, et al. Activity of drugs from traditional Chinese medicine toward sensitive and MDRI- or MRPI-overexpressing multidrug-resistant human CCRF-CEM leukemia cells[J]. Blood Cells Mol Dis, 2002, 28(2): 160-8. |
| [5] | Li F, Ma ZF. The effects and mechanisms of bufalin on the proliferation and apoptosis of PC3 cell line[J].Zhonghua Lin Chuang Yi Xue Za Zhi(Dian Zi Ban), 2011, 5(22): 6594-8. [李锋, 马志方. 蟾蜍灵对前列腺癌PC3细胞增殖和凋亡的作用及其机 制[J]. 中华临床医学杂志(电子版), 2011, 5(22): 6594-8.] |
| [6] | Jia CY, Hu WL, Xu RC, et al. Bufalin induces apoptosis and inhibits proliferation in chronic myeloid leukemia k562 cells[J]. Wu Jing Yi Xue Yuan Xue Bao,2003, 12(4): 265-7. [贾彩云, 呼文 亮, 徐瑞成, 等. 蟾蜍灵对K562细胞生长抑制及凋亡诱导作用[J]. 武警医学院学报, 2003, 12(4): 265-7.] |
| [7] | Li R, Han X, Xu ZW, et al. Effects of bufalin on proliferation, apoptosis and expression of Caspase3, Bcl-2 in EA hy926A cells[J]. Wu Jing Hou Qin Xue Yuan Xue Bao(Yi Xue Ban) 2012, 21(2): 77-80, cover 3-4. [李蓉, 韩香, 徐忠伟, 等. 蟾蜍灵对 EAhy926细胞增殖、凋亡及Caspase3,Bcl-2表达的影响[J]. 武 警后勤学院学报(医学版), 2012, 21(2): 77-80, 封3-4. ] |
| [8] | Tian X, Luo Y, Yan YB, et al. Effect of Bufalin on cellular proliferation and apoptosis in human esophageal squamous carcinoma EC9706 cells[J]. Zhongguo Yi Xue Ke Xue Yuan Xue Bao, 2012, 34(6): 556-62. [田昕, 罗颖, 闫永波, 等. 蟾蜍灵对人 食管鳞癌EC9706细胞增殖及凋亡的影响[J]. 中国医学科学院 学报, 2012, 34(6): 556-62.] |
| [9] | Liang JC, Zhang XH, You SH, et al. Effects of bufalin on the proliferation and expressions of cyclin E and P27 in changliocarcinoma cell line QBC939[J]. Yi Xue Yan Jiu Sheng Xue Bao, 2010, 23(11): 1136-9. [梁军才, 张秀华, 游思洪, 等. 蟾 蜍灵对人胆管癌细胞QBC939增殖及cyclin E和P27蛋白表达影 响的研究[J]. 医学研究生学报, 2010, 23(11): 1136-9.] |
| [10] | Huang WW, Yang JS, Pai SJ. Bufalin induces G(0)/G(1) phase arrest through inhibiting the levels of cyclin D, cyclin E, CDK2 and CDK4, and triggers apoptosis via mitochondrial signaling pathway in T24 human bladder cancer cells[J]. Mutat Res, 2012, 732(1-2): 26-33. |
| [11] | Watabe M, Nakajo S, Yoshida T, et al. Treatment of U937 cells with bufalin induces the translocation of casein kinase 2 and modulates the activity of topoisomeraseⅡ prior to the induction of apoptosis[J]. Cell Growth Differ, 1997, 8(8): 871-9. |
| [12] | Numazawa S, Inoue N, Nakura H, et al. A cardiotonic steroid bufalin-induced differentiation of THP-1 cells. Involvement of Na+, K+-ATPase inhibition in the early changes in proto-oncogene expression[J]. Biochem Pharmacol, 1996, 52(2): 321-9. |
| [13] | Qu XJ, Qu JL, Liu YP, et al. Blockage of NF-κB pathway enhanced bufalin-induced HL-60 cell apoptosis[J]. Xian Dai Zhong Liu Yi Xue, 2009, 17(11): 2039-42. [曲秀娟, 曲晶磊, 刘云 鹏, 等. 抑制NF-κB通路增强蟾蜍灵诱导的HL-60细胞凋亡[J]. 现代肿瘤医学, 2009, 17(11): 2039-42.] |
| [14] | Takai N, Ueda T, Ishii T, et al. Effects of bufalin on the proliferation of human choriocarcinoma cells[J]. Int J Gynecol Cancer, 2011, 21(6): 1105-9. |
| [15] | Yan S, Qu X, Xu C, et al. Down-regulation of Cbl-b by bufalin results in up-regulation of DR4/DR5 and sensitization of TRAILinduced apoptosis in breast cancer cells[J]. J Cancer Res Clin Oncol, 2012, 138(8): 1279-89. |
| [16] | Zhu Z, Sun H, Ma G, et al. Bufalin induces lung cancer cell apoptosis via the inhibition of PI3K/Akt pathway[J]. Int J Mol Sci, 2012, 13(2): 2025-35. |
| [17] | Zhu ZT, Yu YL, Wang K, et al. Effect of Bufalin on proliferation and apoptosis of human non-small cell lung cancer A549 cell[J]. Zhongguo Fei Ai Za Zhi, 2010, 13(9): 841-5. [朱志图, 郁云龙, 王 锴, 等. 蟾蜍灵对人非小细胞肺癌A549细胞增殖与凋亡的影响[J]. 中国肺癌杂志, 2010, 13(9): 841-5.] |
| [18] | Takai N, Kira N, Ishii T. Bufalin, a traditional oriental medicine, induces apoptosis in human cancer cells[J]. Asian Pac J Cancer Prev, 2012, 13(1): 399-402. |
| [19] | Fan J, Zheng S, Zhao G. Effects of bufalin on expression of pololike kinase-1 in colon cancer SW-480 cell line[J]. Zhongguo Bing Li Sheng Li Za Zhi, 2006, 22(3): 491-4. [范钰, 郑树, 赵刚. 蟾蜍 灵对结肠癌SW-480细胞polo-like kinase-1表达及细胞凋亡的影 响[J]. 中国病理生理杂志, 2006, 22(3): 491-4.] |
 2014, Vol. 41
2014, Vol. 41


